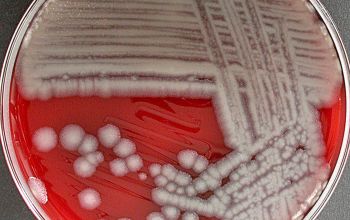
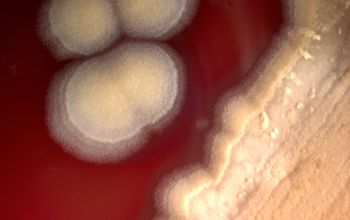

cutaneous anthrax
University Erlangen
Department of Dermatology
phone (+49)9131-85-2727
https://imannooor.wordpress.com/2010/09/05/anthrax/
cutaneous anthrax
eschar
photo: Robert Aylesworth
http://www.webmd.com/skin-problems-and-treatments/cutaneous-anthrax-infection
Under the microscopeone one sees innumerable long, threadlike chains, consisting of bacilli, "Medusa Head"
painted by Garavaggio
Medusa was beheaded by the hero Perseus, who thereafter used her head as a weapon untill he gaved it to the godess Athena to place on her shield
BIOTERRORISM
A letter sent to Senate Majority Leader Tom Daschle containing anthrax powder killed two postal workers
http://www.thetechherald.com/articles/FBI-closes-chapter-on-worst-bioterrorism-case-in-U-S-history/1504/
BIOTERRORISM
Osama Bin Laden used anthrax
photo: Jason Burke
http://www.theguardian.com/world/2011/may/30/osama-bin-laden-militant-alliance
Bacillus anthracis
-
General information
Taxonomy
Family: Bacillaceae
Bacillus cereus group: B. anthracis, B. cereus, B. mycoides, B. thuringiensis
Natural habitats
Soil inhabitant in sporulated form. Anthrax spores in soil can remain infectious for decades.
They are obligate pathogens.
Isolated from blood of animals and human with anthrax, animal carcasses and products and soil contaminated with spores
Clinical significance / ANTHRAX
- cutaneous anthrax
Infection occurs through a break in the skin. Following the incubation period of usually 2 to 3 days, a small papule appears, progressing over the next 24h to a ring of vesicles, with subsequent ulceration and formation of a characteristic blackened eschar.
Subsequent eschar formation may become thick and surrounded by extensive edema.
Fever and pus and pain at the side are normally absent; their presence probably indicate a secondary bacterial infection.
- gastrointestinal anthrax
The symptoms are the result of ulcerations developing primarily in the cecal and terminal ileal mucosae: vomiting, nausea and abdominal pain, accompanied by fever.
This can rapidly progress to bloody diarrhea and systemic infection
- inhalation anthrax / bioterrorism
The inhaled spores are ingested by macrophages and carried from the lungs to the lymphatic system, where the infection progresses.
During transit to lymph nodes, spores germinate into vegetative cells, begin to replicate and produce the capsule and toxins that lead to bacteremia and associated hemorrhage and necrosis.
Anthrax is high on the list of agents that could be used in biological warfare or bioterrorism.
-
Diseases
-
Gram stain
Gram positive rods
1.0-1.3 x 3.0-6.0 µm
(only B.cereus group + B.megaterium >1 µm)
The bacilli tend to occur in chains (appearance of bamboo)
Spore shape: ellipsoidal
Spore position: central of paracentral
Sporangia swelling: negative
Capsule present
Capsule is produced ‘in vivo’ or in blood containing medium, the capsule can be visualized by staining smears India ink
-
Culture characteristics
-
Facultative anaerobic
BA: colonies on agar are large, 6-7 mm diameter, matte, opaque, with a "winding" edge, non-hemolytic or weak hemolytic, non-pigmented.
Under the microscope one sees innumerable long, threadlike chains, consisting of bacilli, "Medusa Head"
Colonies of the capsulate strains appear mucoid
Avirulent strains have no capsule
BBAØ: growth
-
-
Characteristics
-
References
James Versalovic et al.(2011) Manual of Clinical Microbiology 10th Edition
Karen C. Carrol et al (2019) Manual of Clinical Microbiology, 12th Edition